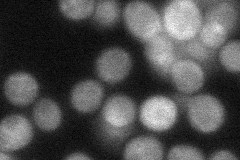
YMR216C

View description
SR protein kinase (SRPK) involved in regulating proteins involved in mRNA metabolism and cation homeostasis; similar to human SRPK1
Localization:
Intensity:
Fold change:
Significance:
-
C’ GFP library in SD

below threshold16.01 -
N' NOP1pr-GFP in SD

cytosol59.0064 -
N' TEF2pr-mCherry in SD

cytosol65.5453 -
N' NATIVEpr-GFP in SD
cytosol44.0263 -
N' TEF2pr-VC and Cyto-VN in SD

cytosol49.3102 -
C’ GFP library in SD+DTT

cytosol17.681.1No -
C’ GFP library in SD+H2O2

cytosol18.721.16No -
C’ GFP library in Starvation Media

cytosol14.460.9No -
C’ GFP library on the background of Pup2-DaMP

below threshold -
C’ GFP library on the background of CCT mutant

below threshold18.27971.14157No
